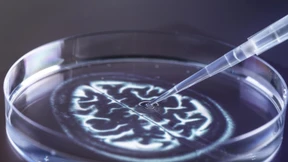
Wie Alzheimer-Biomarker die Therapie verbessern sollen

EU-Behörde lehnt Empfehlung von Alzheimer-Medikament ab
Die EU-Arzneimittelbehörde hat die Zulassung des Alzheimer-Wirkstoffs Lecanemab überraschend abgelehnt. Die Risiken schwerer Nebenwirkungen wie Wassereinlagerungen und Blutungen im Gehirn seien höher zu bewerten als die erwartete positive Wirkung.